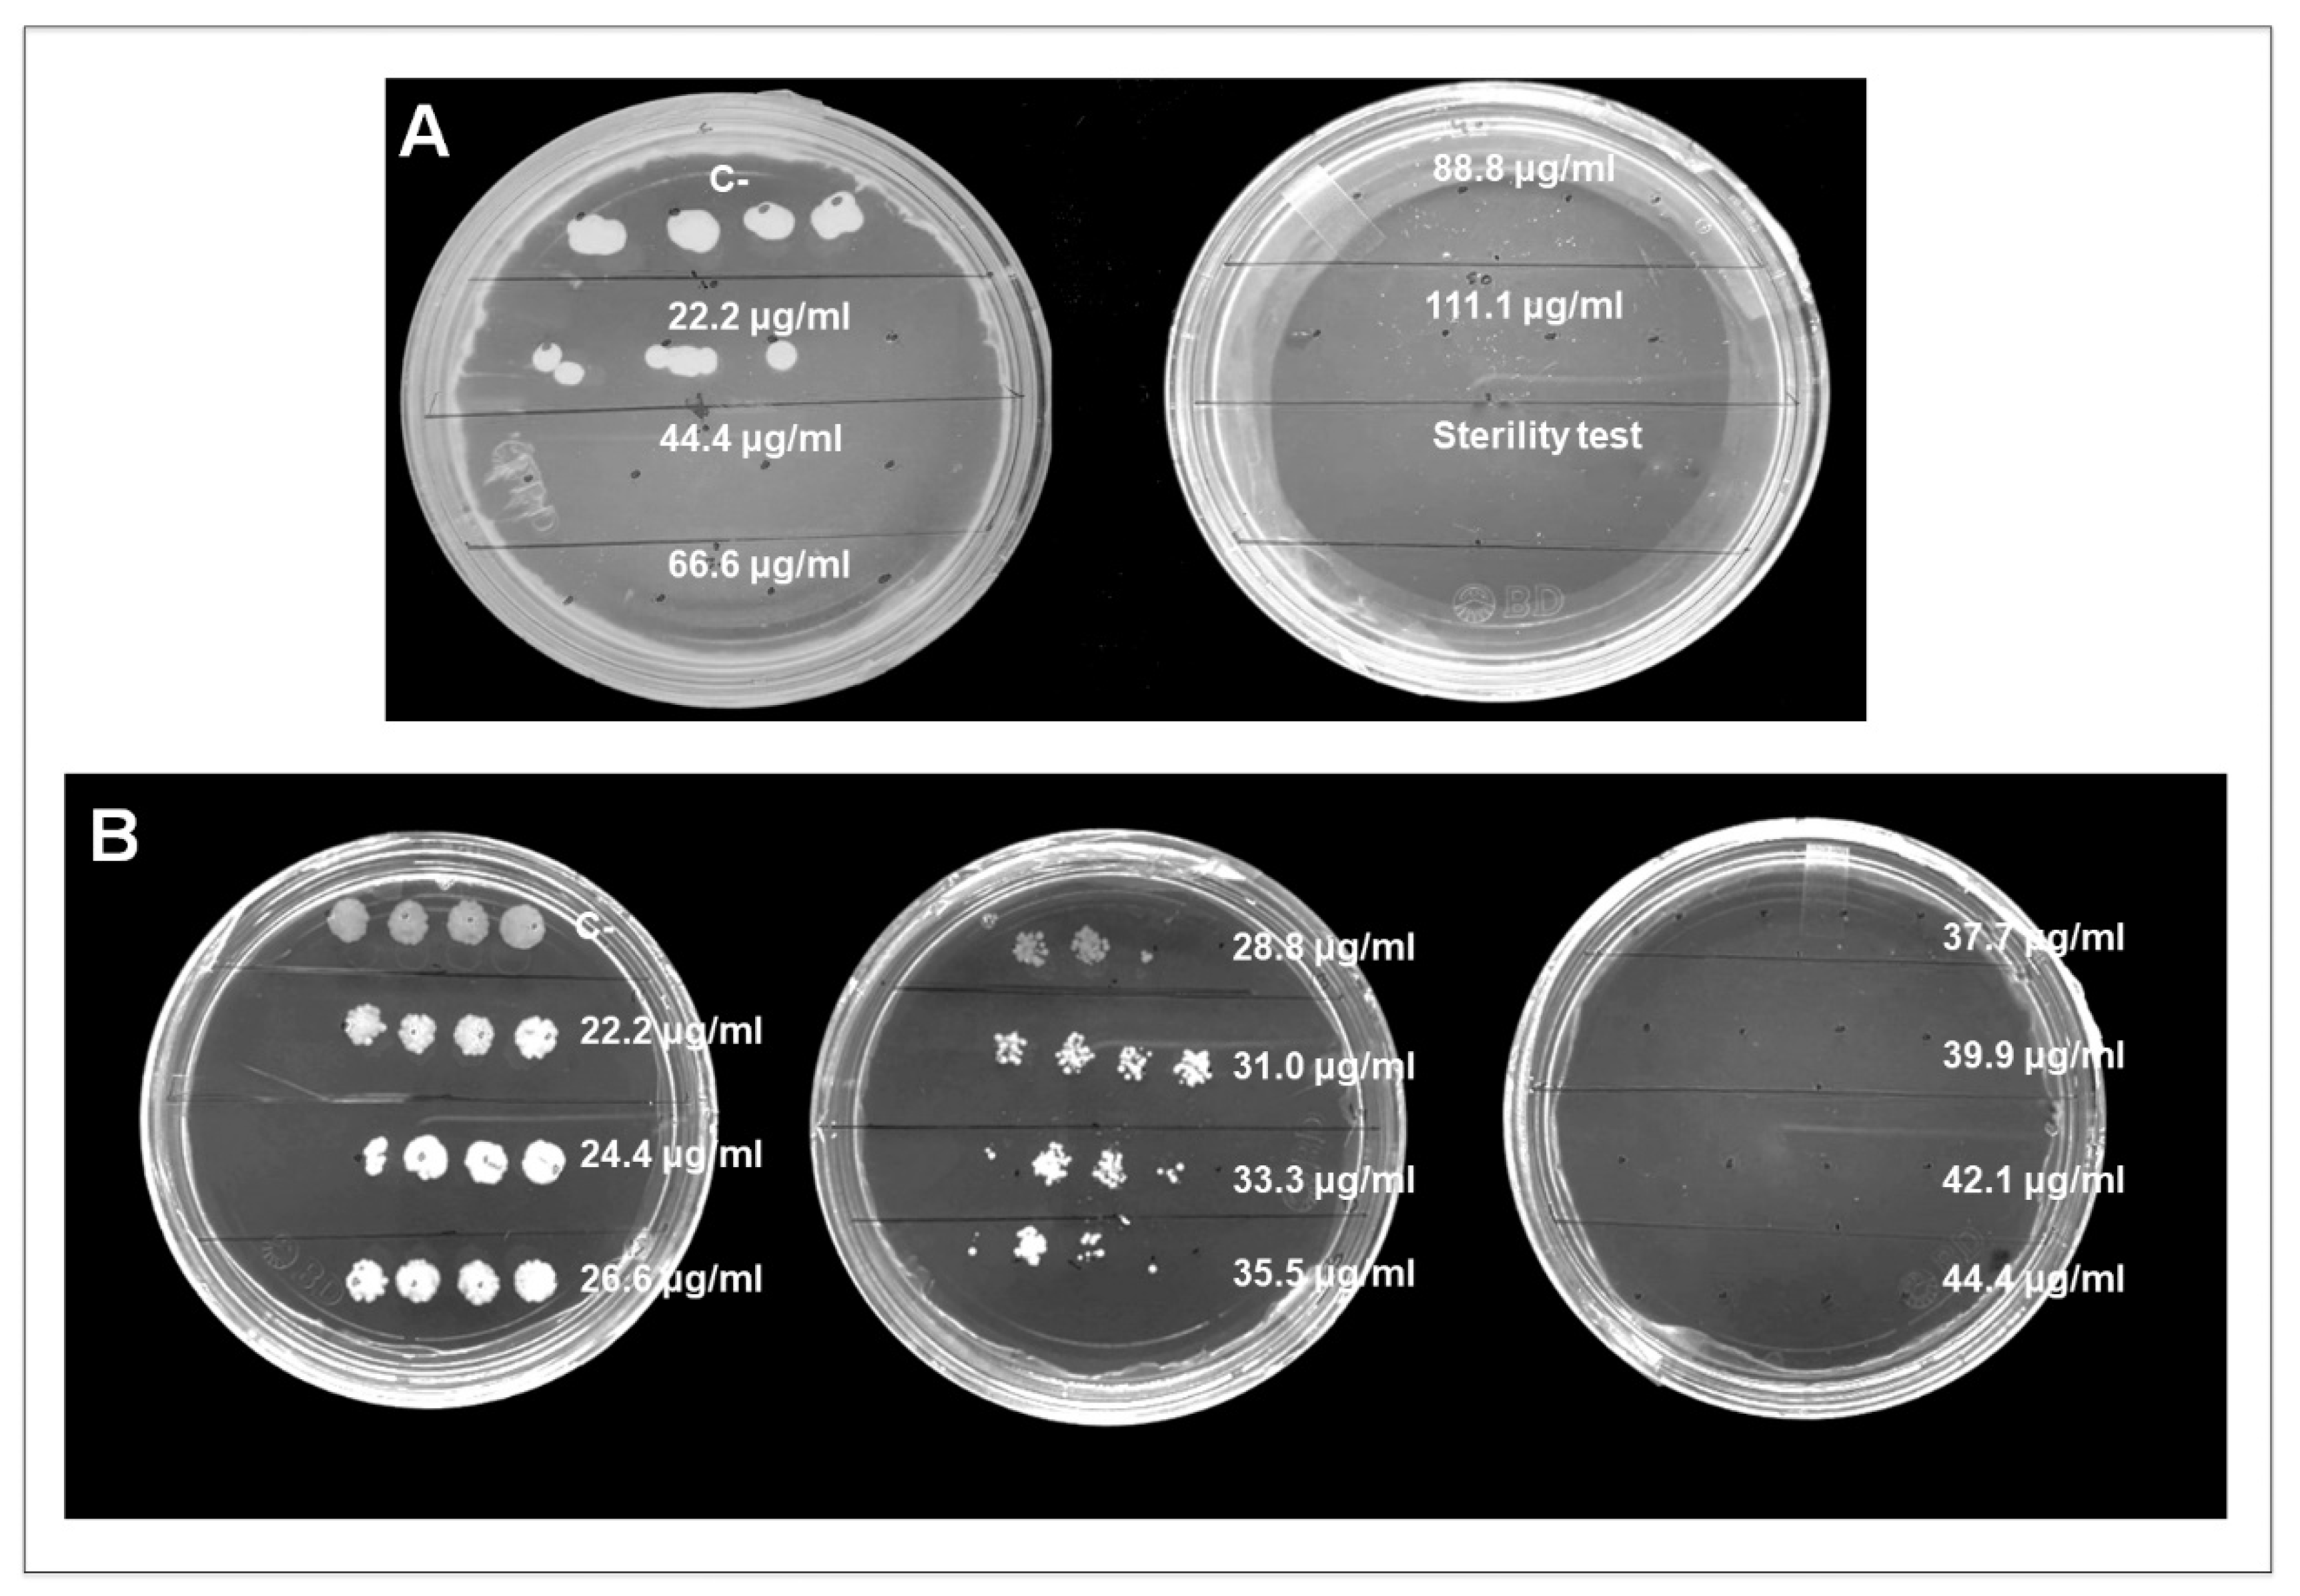
Nanomaterials 12 03856 g005 Nanomaterials 12 03856 g005

Highly Antifungal Activity of Biosynthesized Copper Oxide Nanoparticles against Candida albicans
Abstract
1. Introduction
2. Materials and Methods
2.1. Strain, Media, and Growth Conditions
2.2. Biosynthesis of CuONPs
2.3. Characterization of CuONPs
2.4. FTIR Analysis of Synthesized CuONPs
2.5. Evaluation of Antifungal Capacity
2.6. ROS Production
2.7. Ultrastructural Analysis of C. albicans
2.8. Biocompatibility Evaluation
2.8.1. Cell Viability
2.8.2. Hemolysis
3. Results
3.1. Nanoparticle Characterization
3.2. FTIR Analysis of CuONPs
3.3. Evaluation of the Antifungal Properties of CuONPs against C. albicans
3.4. ROS Production
3.5. Ultrastructural Analysis of C. albicans
3.6. Biocompatibility of CuONPs in Mammalian Cell Lines
3.7. Hemolysis
4. Discussion
5. Conclusions
Author Contributions
Funding
Institutional Review Board Statement
Informed Consent Statement
Data Availability Statement
Acknowledgments
Conflicts of Interest
References
- Biasoli, M. Candidiasis. 2013. Available online: http://www.fbioyf.unr.edu.ar/evirtual/file.php/118/MATERIALES_2013/TEORICOS_20 (accessed on 28 September 2022).
- Silva, S.; Negri, M.; Henriques, M.; Oliveira, R.; Williams, D.W.; Azeredo, J. Candida glabrata, Candida parapsilosis and Candida tropicalis: Biology, epidemiology, pathogenicity and antifungal resistance. FEMS Microbiol. Rev. 2012, 36, 288–305. [Google Scholar] [CrossRef] [PubMed]
- McCullough, M.J.; Ross, B.C.; Reade, P.C. Candida albicans: A review of its history, taxonomy, epidemiology, virulence attributes, and methods of strain differentiation. Int. J. Oral Maxillofac. Surg. 1996, 25, 136–144. [Google Scholar] [CrossRef]
- Arendrup, M.C.; Patterson, T.F. Multidrug-resistant Candida: Epidemiology, molecular mechanisms, and treatment. J. Infect. Dis. 2017, 216, S445–S451. [Google Scholar] [CrossRef] [PubMed]
- Castro-Longoria, E.; Garibo-Ruiz, D.; Martínez-Castro, S. Myconanotechnology to treat infectious diseases: A perspective. In Fungal Nanotechnology; Springer: Berlin/Heidelberg, Germany, 2017; pp. 235–261. [Google Scholar]
- Monteiro, D.R.; Gorup, L.F.; Silva, S.; Negri, M.; de Camargo, E.R.; Oliveira, R.; Barbosa, D.B.; Henriques, M. Silver colloidal nanoparticles: Antifungal effect against adhered cells and biofilms of Candida albicans and Candida glabrata. Biofouling 2011, 27, 711–719. [Google Scholar] [CrossRef] [PubMed]
- Hwang, I.; Lee, J.; Hwang, J.H.; Kim, K.-J.; Lee, D.G. Silver nanoparticles induce apoptotic cell death in Candida albicans through the increase of hydroxyl radicals. FEBS J. 2012, 279, 1327–1338. [Google Scholar] [CrossRef]
- Vazquez-Muñoz, R.; Avalos-Borja, M.; Castro-Longoria, E. Ultrastructural analysis of Candida albicans when exposed to silver nanoparticles. PLoS ONE 2014, 9, e108876. [Google Scholar] [CrossRef]
- Kruk, T.; Szczepanowicz, K.; Stefańska, J.; Socha, R.P.; Warszyński, P. Synthesis and antimicrobial activity of monodisperse copper nanoparticles. Colloids Surf. B Biointerfaces 2015, 128, 17–22. [Google Scholar] [CrossRef]
- Rasool, U.; Sah, S.K.; Hemalatha, S. Effect of biosynthesized copper nanoparticles (CUNPS) on the growth and biofilm formation of fluconazole-resistant Candida albicans. J. Microbiol. Biotechnol. Food Sci. 2021, 2021, 21–24. [Google Scholar] [CrossRef]
- Dhillon, G.S.; Brar, S.K.; Kaur, S.; Verma, M. Green approach for nanoparticle biosynthesis by fungi: Current trends and applications. Crit. Rev. Biotechnol. 2012, 32, 49–73. [Google Scholar] [CrossRef]
- Magdi, H.M.; Mourad MH, E.; El-Aziz MM, A. Biosynthesis of silver nanoparticles using fungi and biological evaluation of mycosynthesized silver nanoparticles. Egypt J. Exp. Biol. Bot. 2014, 10, 1–12. [Google Scholar]
- CLSI. Reference Method for Broth Dilution Antifungal Susceptibility Testing of Yeasts; CLSI: Malvern, PA, USA, 2002; p. M27-A2. [Google Scholar]
- CLSI. Method for Antifungal Disk Diffusion Susceptibility Testing of Yeasts, 3rd ed.; CLSI: Malvern, PA, USA, 2018; p. M44. [Google Scholar]
- ISO 10993-4:2017; Biological Evaluation of Medical Devices—Part 4: Selection of Tests for Interactions with Blood. ISO: Geneva, Switzerland, 2017.
- Berra, D.; Laouini, S.E.; Benhaoua, B.; Ouahrani, M.R.; Berrani, D.; Rahal, A. Green synthesis of copper oxide nanoparticles by Pheonix dactylifera L leaves extract. Dig. J. Nanomater. Biostruct. 2018, 13, 1231–1238. [Google Scholar]
- Whaley, S.G.; Berkow, E.L.; Rybak, J.M.; Nishimoto, A.T.; Barker, K.S.; Rogers, P.D. Azole antifungal resistance in Candida albicans and emerging non-albicans candida species. Front. Microbiol. 2017, 7, 2173. [Google Scholar] [CrossRef] [PubMed]
- Aziz, W.J.; Jassim, H.A. A new paradigm shift to prepare copper nanoparticles using biological synthesis and evaluation of antimicrobialactivity. Plant Arch. 2018, 18, 2020–2024. [Google Scholar]
- Ingle, A.P.; Duran, N.; Rai, M. Bioactivity, mechanism of action, and cytotoxicity of copper-based nanoparticles: A review. Appl. Microbiol. Biotechnol. 2014, 98, 1001–1009. [Google Scholar] [CrossRef] [PubMed]
- Din, M.I.; Rehan, R. Synthesis, characterization, and applications of copper nanoparticles. Anal. Lett. 2017, 50, 50–62. [Google Scholar] [CrossRef]
- Shobha, G.; Moses, V.; Ananda, S. Biological synthesis of copper nanoparticles and its impact—A review. Int. J. Pharm. Sci. Invent. 2014, 3, 29–30. [Google Scholar]
- Besold, A.N.; Culbertson, E.M.; Culotta, V.C. The yin and yang of copper during infection. J. Biol. Inorg. Chem. 2016, 21, 137–144. [Google Scholar] [CrossRef]
- Varshney, R.; Bhadauria, S.; Gaur, M.S.; Pasricha, R. Characterization of copper nanoparticles synthesized by a novel microbiological method. Jom 2010, 62, 102–104. [Google Scholar] [CrossRef]
- Suresh, Y.; Annapurna, S.; Bhikshamaiah, G.; Singh, A.K. Characterization of green synthesized copper nanoparticles: A novel approach. In Proceedings of the International Conference on “Advanced Nanomaterials and Emerging Engineering Technologies” (ICANMEET), Chennai, India, 24–26 July 2013; pp. 63–67. [Google Scholar]
- Mali, S.C.; Dhaka, A.; Githala, C.K.; Trivedi, R. Green synthesis of copper nanoparticles using Celastrus paniculatus Willd. leaf extract and their photocatalytic and antifungal properties. Biotechnol. Rep. 2020, 27, e00518. [Google Scholar] [CrossRef]
- Cuevas, R.; Durán, N.; Diez, M.C.; Tortella, G.R.; Rubilar, O. Extracellular biosynthesis of copper and copper oxide nanoparticles by Stereum hirsutum, a native white-rot fungus from chilean forests. J. Nanomater. 2015, 2015, 789089. [Google Scholar] [CrossRef]
- Sriramulu, M.; Shanmugam, S.; Ponnusamy, V.K. Agaricus bisporus mediated biosynthesis of copper nanoparticles and its biological effects: An in-vitro study. Colloids Interface Sci. Commun. 2020, 35, 100254. [Google Scholar] [CrossRef]
- Jorge de Souza, T.A.; Rosa Souza, L.R.; Franchi, L.P. Silver nanoparticles: An integrated view of green synthesis methods, transformation in the environment, and toxicity. Ecotoxicol. Environ. Saf. 2019, 171, 691–700. [Google Scholar] [CrossRef] [PubMed]
- Bhattacharjee, S. DLS and zeta potential–what they are and what they are not? J. Control. Release 2016, 235, 337–351. [Google Scholar] [CrossRef]
- Socrates, G. Infrared and Raman Characteristic Group Frequencies: Tables and Charts; John Wiley & Sons: Hoboken, NJ, USA, 2004. [Google Scholar]
- El-Moslamy, S.H.; Elkady, M.F.; Rezk, A.H.; Abdel-Fattah, Y.R. Applying Taguchi design and large-scale strategy for mycosynthesis of nano-silver from endophytic Trichoderma harzianum SYA. F4 and its application against phytopathogens. Sci. Rep. 2017, 7, 45297. [Google Scholar] [CrossRef] [PubMed]
- Ahluwalia, V.; Kumar, J.; Sisodia, R.; Shakil, N.A.; Walia, S. Green synthesis of silver nanoparticles by Trichoderma harzianum and their bio-efficacy evaluation against Staphylococcus aureus and Klebsiella pneumonia. Ind. Crops Prod. 2014, 55, 202–206. [Google Scholar] [CrossRef]
- Murillo-Rábago, E.I.; Vilchis-Nestor, A.R.; Juarez-Moreno, K.; Garcia-Marin, L.E.; Quester, K.; Castro-Longoria, E. Optimized synthesis of small and stable silver nanoparticles using intracellular and extracellular components of fungi: An alternative for bacterial inhibition. Antibiotics 2022, 11, 800. [Google Scholar] [CrossRef]
- Celebi, O.; Cinisli, K.T.; Celebi, D. Antimicrobial activity of the combination (Nano-Bio) of Artemisia absinthium with copper nanoparticles. Mater. Today Proc. 2022, 45, 3809–3813. [Google Scholar] [CrossRef]
- Dashtizadeh, Z.; Jookar Kashi, F.; Ashrafi, M. Phytosynthesis of copper nanoparticles using Prunus mahaleb L. and its biological activity. Mater. Today Commun. 2021, 27, 102456. [Google Scholar] [CrossRef]
- Das, P.E.; Abu-Yousef, I.A.; Majdalawieh, A.F.; Narasimhan, S.; Poltronieri, P. Green synthesis of encapsulated copper nanoparticles using a hydroalcoholic extract of moringa oleifera leaves and assessment of their antioxidant and antimicrobial activities. Molecules 2020, 25, 555. [Google Scholar] [CrossRef]
- Padmavathi, A.R.; Murthy, S.S.; Das, A.; Priya, A.; Sushmitha, T.J.; Pandian, S.K.; Toleti, S.R. Impediment to growth and yeast-to-hyphae transition in Candida albicans by copper oxide nanoparticles. Biofouling 2020, 36, 56–72. [Google Scholar] [CrossRef]
- Hassanien, R.; Husein, D.Z.; Al-Hakkani, M.F. Biosynthesis of copper nanoparticles using aqueous Tilia extract: Antimicrobial and anticancer activities. Heliyon 2018, 4, e01077. [Google Scholar] [CrossRef] [PubMed]
- Allahverdiyev, A.M.; Kon, K.V.; Abamor, E.S.; Bagirova, M.; Rafailovich, M. Coping with antibiotic resistance: Combining nanoparticles with antibiotics and other antimicrobial agents. Expert Rev. Anti Infect. Ther. 2011, 9, 1035–1052. [Google Scholar] [CrossRef]
- Ray, P.D.; Huang, B.-W.; Tsuji, Y. Reactive oxygen species (ROS) homeostasis and redox regulation in cellular signaling. Cell Signal 2012, 24, 981–990. [Google Scholar] [CrossRef] [PubMed]
- Zheng, W.L.; Wang, B.J.; Wang, L.; Shan, Y.P.; Zou, H.; Song, R.L.; Wang, T.; Gu, J.H.; Yuan, Y.; Liu, Z.-P. ROS-mediated cell cycle arrest and apoptosis induced by zearalenone in mouse sertoli cells via ER stress and the ATP/AMPK Pathway. Toxins 2018, 10, 24. [Google Scholar] [CrossRef]
- Rodrigues, M.L. The multifunctional fungal ergosterol. MBio 2018, 9, e01755-18. [Google Scholar] [CrossRef] [PubMed]
- Martínez, A.; Apip, C.; Meléndrez, M.F.; Domínguez, M.; Sánchez-Sanhueza, G.; Marzialetti, T.; Catalán, A. Dual antifungal activity against Candida albicans of copper metallic nanostructures and hierarchical copper oxide marigold-like nanostructures grown in situ in the culture medium. J. Appl. Microbiol. 2021, 130, 1883–1892. [Google Scholar] [CrossRef]
- Chen, Z.; Meng, H.; Xing, G.; Chen, C.; Zhao, Y.; Jia, G.; Wang, T.; Yuan, H.; Ye, C.; Zhao, F.; et al. Acute toxicological effects of copper nanoparticles in vivo. Toxicol. Lett. 2006, 163, 109–120. [Google Scholar] [CrossRef]
- Ameh, T.; Sayes, C.M. The potential exposure and hazards of copper nanoparticles: A review. Environ. Toxicol. Pharmacol. 2019, 71, 103220. [Google Scholar] [CrossRef]
- Farooq, M.A.; Xinyu, H.; Jabeen, A.; Ahsan, A.; Seidu, T.A.; Kutoka, P.T.; Wang, B. Enhanced cellular uptake and cytotoxicity of vorinostat through encapsulation in TPGS-modified liposomes. Colloids Surf. B Biointerfaces 2021, 199, 111523. [Google Scholar] [CrossRef]
- Ahmed, H.A.; Aboul-Enein, A.M.; Abou-Elella, F.; Salem, S.H.; Aly, H.F.; Nassrallh, A.; Salama, Z.A. Nano-formulations of hesperidin and essential oil extracted from sweet orange peel: Chemical properties and biological activities. Egypt. J. Chem. 2021, 64, 5383–5395. [Google Scholar] [CrossRef]
- Ghuglot, R.; Titus, W.; Agnihotri, A.S.; Krishnakumar, V.; Krishnamoorthy, G.; Marimuthu, N. Stable copper nanoparticles as potential antibacterial agent against aquaculture pathogens and human fibroblast cell viability. Biocatal. Agric. Biotechnol. 2021, 32, 101932. [Google Scholar] [CrossRef]
- Valodkar, M.; Rathore, P.S.; Jadeja, R.N.; Thounaojam, M.; Devkar, R.V.; Thakore, S. Cytotoxicity evaluation and antimicrobial studies of starch capped water soluble copper nanoparticles. J. Hazard. Mater. 2012, 201–202, 244–249. [Google Scholar] [CrossRef] [PubMed]
- Gondwal, M.; Pant, G.J.N. Synthesis and catalytic and biological activities of silver and copper nanoparticles using cassia occidentalis. Int. J. Biomater. 2018, 2018, 1–10. [Google Scholar] [CrossRef] [PubMed]

Publisher’s Note: MDPI stays neutral with regard to jurisdictional claims in published maps and institutional affiliations. |
© 2022 by the authors. Licensee MDPI, Basel, Switzerland. This article is an open access article distributed under the terms and conditions of the Creative Commons Attribution (CC BY) license (https://creativecommons.org/licenses/by/4.0/).
Share and Cite
Garcia-Marin, L.E.; Juarez-Moreno, K.; Vilchis-Nestor, A.R.; Castro-Longoria, E. Highly Antifungal Activity of Biosynthesized Copper Oxide Nanoparticles against Candida albicans. Nanomaterials 2022, 12, 3856. https://doi.org/10.3390/nano12213856
Garcia-Marin LE, Juarez-Moreno K, Vilchis-Nestor AR, Castro-Longoria E. Highly Antifungal Activity of Biosynthesized Copper Oxide Nanoparticles against Candida albicans. Nanomaterials. 2022; 12(21):3856. https://doi.org/10.3390/nano12213856
Chicago/Turabian StyleGarcia-Marin, Luis Enrique, Karla Juarez-Moreno, Alfredo Rafael Vilchis-Nestor, and Ernestina Castro-Longoria. 2022. "Highly Antifungal Activity of Biosynthesized Copper Oxide Nanoparticles against Candida albicans" Nanomaterials 12, no. 21: 3856. https://doi.org/10.3390/nano12213856
APA StyleGarcia-Marin, L. E., Juarez-Moreno, K., Vilchis-Nestor, A. R., & Castro-Longoria, E. (2022). Highly Antifungal Activity of Biosynthesized Copper Oxide Nanoparticles against Candida albicans. Nanomaterials, 12(21), 3856. https://doi.org/10.3390/nano12213856










